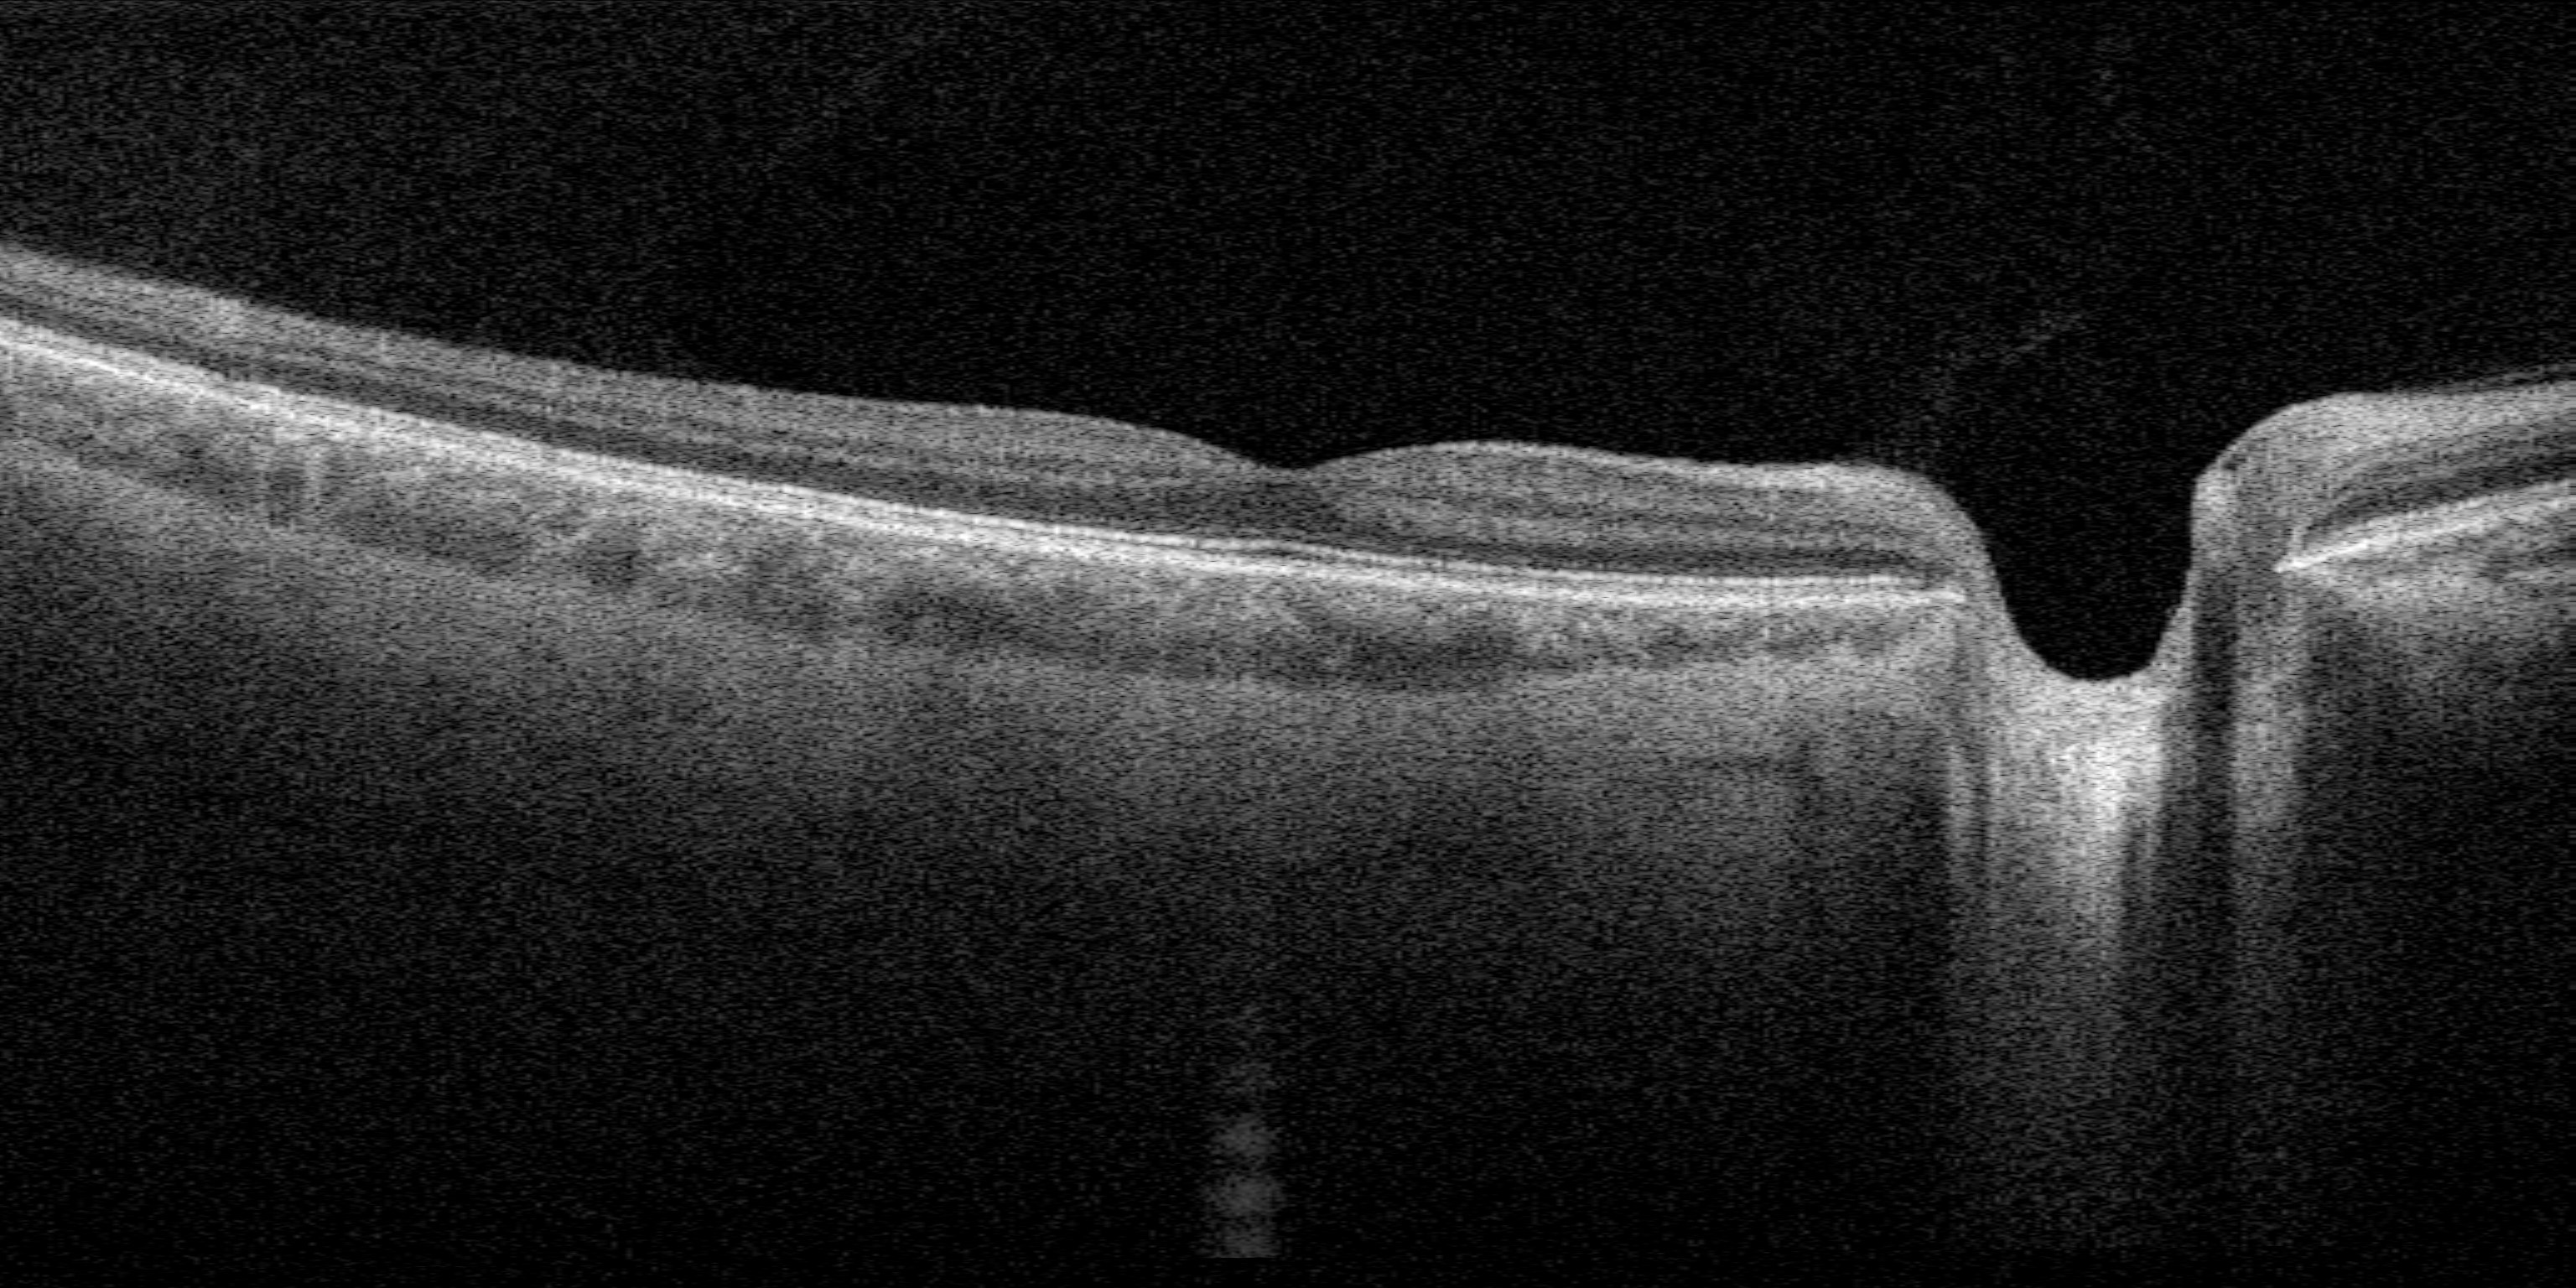
Abbildung der Netzhaut des Auges

Young Talents - Science and Music
The event series offers comprehensible lectures on current research by young scientists at KIT. Afterwards, young musicians perform a concert program, mostly chamber music.
The programs are curated and organized by KIT's event management in cooperation with the Förderverein für Kunst, Medien und Wissenschaft e.V. (Association for the Promotion of Art, Media and Science). The KIT Freundeskreis und Fördergesellschaft e.V. has also been involved since 2022.
Occasionally, the KIT art curator, Andrea Stengel, also offers short art tours to one of the numerous works of art in front of or inside KIT buildings shortly before the event begins.
Below you will find a preview of the program of the next edition as well as a link to all the episodes that could only be shown on KIT's YouTube channel during the 2020/21 pandemic.
You can see a compilation of various episodes broadcast online below. The event management of KIT would like to thank Christian Wetzel from ZML for the great work on this compilation and the support in implementing the format on YouTube.
20251129-Junge Talente c Silke Walz KIT (1)
20251129-Junge Talente c Silke Walz KIT (3)
20251129-Junge Talente c Silke Walz KIT (4)
20251129-Junge Talente c Silke Walz KIT (5)
20251129-Junge Talente c Silke Walz KIT (7)
20251129-Junge Talente c Silke Walz KIT (8)
20251129-Junge Talente c Silke Walz KIT (9)
20251129-Junge Talente c Silke Walz KIT (10)
20251129-Junge Talente c Silke Walz KIT (11)
20251129-Junge Talente c Silke Walz KIT (12)
20251129-Junge Talente c Silke Walz KIT (13)
20251129-Junge Talente c Silke Walz KIT (14)
20251129-Junge Talente c Silke Walz KIT (15)
20251129-Junge Talente c Silke Walz KIT (16)
20251129-Junge Talente c Silke Walz KIT (17)
20251129-Junge Talente c Silke Walz KIT (18)
20251129-Junge Talente c Silke Walz KIT (19)
20251129-Junge Talente c Silke Walz KIT (20)
20251129-Junge Talente c Silke Walz KIT (21)
20251129-Junge Talente c Silke Walz KIT (22)
20251129-Junge Talente c Silke Walz KIT (23)
20251129-Junge Talente c Silke Walz KIT (24)
20251129-Junge Talente c Silke Walz KIT (25)
20251129-Junge Talente c Silke Walz KIT (26)
20251129-Junge Talente c Silke Walz KIT (27)
20251129-Junge Talente c Silke Walz KIT (28)
20251129-Junge Talente c Silke Walz KIT (29)
20251129-Junge Talente c Silke Walz KIT (30)
20251129-Junge Talente c Silke Walz KIT (31)
20251129-Junge Talente c Silke Walz KIT (32)
20251129-Junge Talente c Silke Walz KIT (33)
20251129-Junge Talente c Silke Walz KIT (34)
20251129-Junge Talente c Silke Walz KIT (35)
20251129-Junge Talente c Silke Walz KIT (36)
20251129-Junge Talente c Silke Walz KIT (37)

The series was presented online from 03/20 to 07/21. Here you can find the issues in our
YouTube Playlist
Subscribe to the KIT event calendar and never miss an episode again:
subscribe